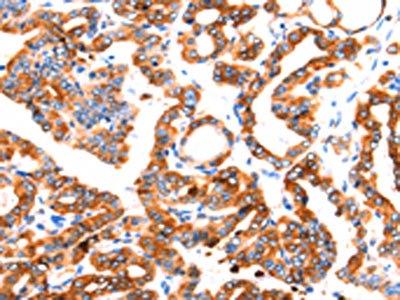

SEPT4 Antibody
-
中文名稱:SEPT4兔多克隆抗體
-
貨號:CSB-PA113302
-
規格:¥1100
-
圖片:
-
The image on the left is immunohistochemistry of paraffin-embedded Human liver cancer tissue using CSB-PA113302(SEPT4 Antibody) at dilution 1/50, on the right is treated with synthetic peptide. (Original magnification: ×200)
-
The image on the left is immunohistochemistry of paraffin-embedded Human thyroid cancer tissue using CSB-PA113302(SEPT4 Antibody) at dilution 1/50, on the right is treated with synthetic peptide. (Original magnification: ×200)
-
-
其他:
產品詳情
-
Uniprot No.:
-
基因名:
-
別名:Apoptosis-related protein in the TGF-beta signaling pathway antibody; ARTS antibody; Bradeion antibody; Bradeion beta antibody; Brain protein H5 antibody; CE5B3 antibody; CE5B3 beta antibody; Cell division control-related protein 2 antibody; Cerebral protein 7 antibody; H5 antibody; hCDCREL-2 antibody; hucep-7 antibody; MART antibody; Peanut-like protein 2 antibody; PNUTL2 antibody; SEP 4 antibody; SEP4 antibody; Sept4 antibody; SEPT4_HUMAN antibody; Septin M antibody; Septin-4 antibody
-
宿主:Rabbit
-
反應種屬:Human
-
免疫原:Synthetic peptide of Human SEPT4
-
免疫原種屬:Homo sapiens (Human)
-
標記方式:Non-conjugated
-
抗體亞型:IgG
-
純化方式:Antigen affinity purification
-
濃度:It differs from different batches. Please contact us to confirm it.
-
保存緩沖液:-20°C, pH7.4 PBS, 0.05% NaN3, 40% Glycerol
-
產品提供形式:Liquid
-
應用范圍:ELISA,IHC
-
推薦稀釋比:
Application Recommended Dilution ELISA 1:1000-1:5000 IHC 1:50-1:200 -
Protocols:
-
儲存條件:Upon receipt, store at -20°C or -80°C. Avoid repeated freeze.
-
貨期:Basically, we can dispatch the products out in 1-3 working days after receiving your orders. Delivery time maybe differs from different purchasing way or location, please kindly consult your local distributors for specific delivery time.
-
用途:For Research Use Only. Not for use in diagnostic or therapeutic procedures.
相關產品
靶點詳情
-
功能:Filament-forming cytoskeletal GTPase (Probable). Plays an important role in male fertility and sperm motility. During spermiogenesis, essential for the establishment of the annulus (a fibrous ring structure connecting the midpiece and the principal piece of the sperm flagellum) which is a requisite for the structural and mechanical integrity of the sperm. Involved in the migration of cortical neurons and the formation of neuron leading processes during embryonic development.; Required for the induction of cell death mediated by TGF-beta and possibly by other apoptotic stimuli. Induces apoptosis through binding and inhibition of XIAP resulting in significant reduction in XIAP levels, leading to caspase activation and cell death.
-
基因功能參考文獻:
- In this review, we will discuss the recent advances of the tauopathy research, primarily focusing on its association with the early axonal manifestation of axonal transport defect, axonal mitochondrial stress, autophagic vesicle accumulation and the proceeding of axon destruction, and the pathogenic Tau spreading across the synapse. PMID: 29991349
- Septin4 is a novel essential factor involved in oxidative stress induced vascular endothelial cell injury by interacting with apoptosis-related protein PARP1. PMID: 29366480
- The data suggest that Sept4_i1 induces hepatic stellate cell apoptosis by inhibiting Akt and Bcl-2 expression and up-regulating PPAR-gamma expression. PMID: 25527525
- results suggest that Septin4 may be involved in the process of activation of hepatic stellate cells by lipopolysaccharide stimulation. PMID: 23180367
- Bradeion/SEPT4 transcript levels are significantly increased in patients with transitional cell bladder cancer.We hypothesize that Bradeion is directly involved in bladder cancer pathogenesis with the highest expression at early cancer stages. PMID: 22503047
- Identification of a novel anti-apoptotic E3 ubiquitin ligase that ubiquitinates antagonists of inhibitor of apoptosis proteins SMAC, HtrA2, and ARTS. PMID: 23479728
- these data suggests a tumor suppressor role of SEPT4_i1 in HCC through regulating hepatocellular carcinoma cell apoptosis. PMID: 21952823
- The expression of SEPT4 is significantly decreased in the ejaculated sperm of idiopathic asthenozoospermia patients. PMID: 21898991
- ARTS is localized at mitochondria and promotes programmed cell death (apoptosis). PMID: 21824006
- role of Bradeion in colorectal neoplasms PMID: 12032658
- Sept4 is involved in the formation of cytoplasmic inclusions as well as induction of cell death in alpha-synuclein-associated neurodegenerative disorders. PMID: 12695511
- Data suggest that ARTS induces apoptosis by antagonizing IAPs, including XIAP. PMID: 15029247
- SEPT8 and SEPT4 are localized surrounding alpha-granules. Activation of platelets by agonists resulted in the translocation of SEPT4 and SEPT8 to the platelet surface indicating a possible functional role of these proteins in platelet granular secretion PMID: 15116257
- ARTS can function as a tumor suppressor protein in childhood acute lymphocytic leukemia. PMID: 15122323
- high cellular levels of ARTS protein sensitize cells toward apoptosis PMID: 15837787
- The data presented here suggest that ARTS P-loop is not frequently mutated in gastric, lung, and hepatocellular carcinomas, and that apoptosis deregulation in cancers is not dependent on the mutation of ARTS gene. PMID: 16376484
- Finds somatic mutation in P-loop domains of proapoptotic ARTS genes uncommon in colon cancers. PMID: 16464805
- define explicitly and characterize the domains of human SEPT4 PMID: 17105210
- The Sept4 may be involved in PD as a dual susceptibility factor, as its insufficiency can diminish dopaminergic neurotransmission and enhance alpha-synuclein neurotoxicity. PMID: 17296554
- interaction of kaposin A protein and the septin 4 variant was suggested as playing a possible role in the development of HHV-8-associated malignancies PMID: 17383018
- SEPT9 sequence alternations causing hereditary neuralgic amyotrophy are associated with altered interactions with SEPT4/SEPT11 and resistance to Rho/Rhotekin-signaling PMID: 17546647
- This protein may play an important role in the pathogenesis of schizophrenia and could be used as a marker for this disease. PMID: 17644312
- Data report an intermediate structure of the GTPase domain of human SEPT4 (SEPT4-G) during unfolding transitions induced by temperature. PMID: 17764158
- The stability and aggregation properties of the GTPase domain from human SEPT4. PMID: 18617022
- Sporadic PD cases showed a statistically significant decrease of the fold change (FC) of SEPT4 (FC = 0.67, P = 0.054) gene expressions in the substantia nigra & amygdala (SEPT4: FC = 0.32, P = 0.007) versus healthy controls. PMID: 18951507
- structural defects in sperm are not caused by abnormal transcription or point mutations of the TAT1 and SEPT4 genes; however, although both proteins are expressed, they are not properly localized at sperm annulus PMID: 19221096
顯示更多
收起更多
-
亞細胞定位:Cytoplasm. Cell projection, cilium, flagellum. Cytoplasmic vesicle, secretory vesicle. Cell projection, axon. Cell projection, dendrite. Perikaryon.; [Isoform ARTS]: Mitochondrion. Nucleus.
-
蛋白家族:TRAFAC class TrmE-Era-EngA-EngB-Septin-like GTPase superfamily, Septin GTPase family
-
組織特異性:Widely expressed in adult and fetal tissues with highest expression in adult brain (at protein level), heart, liver and adrenal gland and fetal heart, kidney, liver and lung. Also expressed in colorectal cancers and malignant melanomas. Expressed in plate
-
數據庫鏈接:
Most popular with customers
-
-
YWHAB Recombinant Monoclonal Antibody
Applications: ELISA, WB, IHC, IF, FC
Species Reactivity: Human, Mouse, Rat
-
Phospho-YAP1 (S127) Recombinant Monoclonal Antibody
Applications: ELISA, WB, IHC
Species Reactivity: Human
-
-
-
-
-